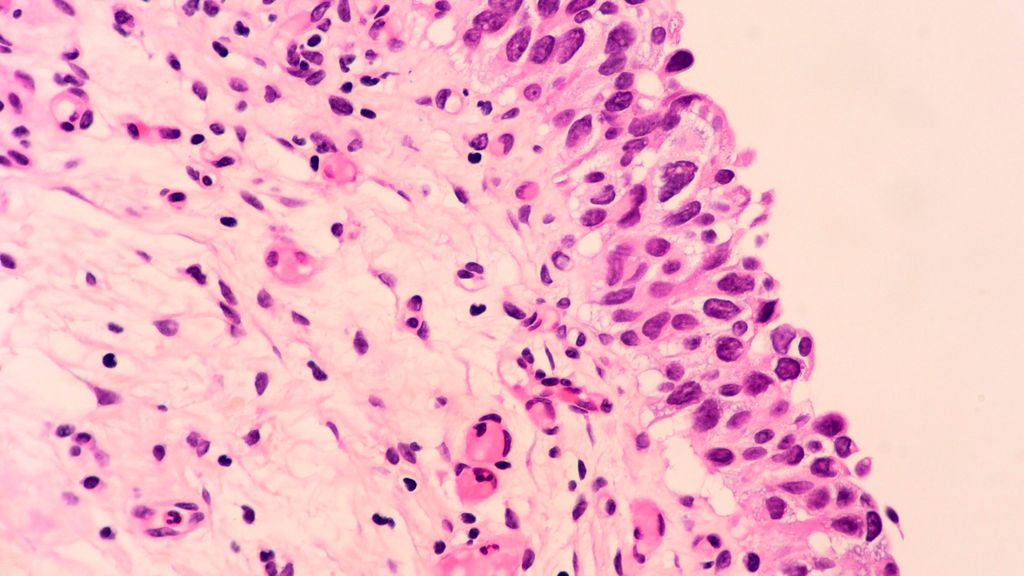

Vom Siegeszug der ADC und von neuen Active-Surveillance-Therapieansätzen
Bericht:
Dr. rer. net. Torsten U. Banisch
Auf dem 11. Michael J. Marberger Meeting der Universitätsklinik für Urologie, Medizinische Universität Wien, wurden aktuelle Daten zu Antikörper-Wirkstoff-Konjugaten, neue Ansätze zum Blasenerhalt beim MBIC und die ersten neuen Therapien seit 40 Jahren im Setting des NMIBC zum Urothelkarzinom vorgestellt.
Antikörper-Wirkstoff-Konjugate
„Antikörper-Wirkstoff-Konjugate (ADC) haben in den letzten Jahren viele Therapiefelder revolutioniert“, eröffnete Prof. Dr. Jonathan Rosenberg vom Weill Cornell Medical College in den USA seinen Vortrag. Die Antikörperkomponente des ADC vermittelt dabei die Tumorspezifizität des Wirkstoffs und ist über einen Linker an das Payload gebunden, das in der Tumorzelle freigesetzt wird und zytotoxisch aktiv ist.1 Als Zielprotein im Urothelkarzinom (UC) wird oftmals das Zelladhäsionsprotein Nectin-4 anvisiert, da es auf UC-Zellen überexprimiert ist. In gesunden Geweben ist Nectin-4 vornehmlich auf Hautzellen nachzuweisen.2 Ein aktueller Nectin-4-gerichteter ADC ist Enfortumab-Vedotin (EV), bei dem die Mikrotubuli-hemmende Substanz Monomethyl-Auristatin-E (MMAE) die zytotoxische Komponente darstellt. Nach Internalisierung des Wirkstoffs in die Tumorzelle kommt es zur Apoptose und zu einer Freisetzung des Wirkstoffs aus der Zelle, wo er, was als „Bystander-Effekt“ bezeichnet wird, auch benachbarte Tumorzellen erreicht.3,4
In der Phase-I-Studie EV-101 konnte unter einer EV-Dosis von 1,25mg/kg bereits ein Gesamtansprechen (ORR) von 43% und eine Komplettremission (CR) bei 5% der Patient:innen erreicht werden. Diese Daten wurden durch die anschließende Phase-II-Studie EV-201 bestätigt. Hier erhielten alle Patient:innen vorausgehend eine platinhaltige Chemotherapie (CT) und einen Immuncheckpoint-Inhibitor (ICI) und zeigten eine ORR von 44%. Das progressionsfreie Überleben (PFS) lag bei 5,8 Monaten und das Gesamtüberleben (OS) lag bei 11,7 Monaten.4,5 Die Phase-III-Studie EV-301 verglich EV plus CT plus ICI in der Drittlinie mit CT plus ICI und erzielte eine OS-Verlängerung von 8,97 Monaten auf 12,88 Monate im EV-Arm. Das Ansprechen war von 17,9% auf 40,6% erhöht.6 Auf Grundlage dieser Daten erfolgte 2022 die EMA-Zulassung von EV als Monotherapie bei erwachsenen Patient:innen mit lokal fortgeschrittenem oder metastasiertem UC, die zuvor eine platinhaltige CT und einen PD-R1- oder PD-L1-Inhibitor erhalten haben.7 In der anschließenden EV-302-Studie wurde eine Kombinationstherapie aus EV plus Pembrolizumab in der Erstlinie bei fortgeschrittenem UC untersucht. Hier konnte im Vergleich zu einer CT eine PFS-Verlängerung von 12,5 Monaten auf 63 Monate und nahezu eine Verdopplung des OS von 16,1 Monaten auf 31,5 Monate ermittelt werden, was die Therapie zum neuen Standard machte.8
Ausblick: eine neue ADC-Generation
Diese Erfolge waren die Grundlage für neue Entwicklungen im Therapiefeld, wie einer neuen Generation von ADC und neuen Ansätzen zur Anvisierung von Nectin-4.1 Zudem bestehen Bemühungen, die ADC-Zytostatika zu verbessern, da unter MMAE auch Toxizitäten auftreten. So wurde für den Nectin4-ADC 9MW2821 ein optimierter Linker entwickelt, der stärker an das Payload bindet und in einer Phase-I/IIa-Studie eine hohe Aktivität zeigen konnte.9 Neben Nectin-4 werden auch TROP2-ADC wie Datopotamab-Deruxtecan erforscht. Dieser zeigte in der Phase-I-Studie TROPION-Pan-Tumor-1 eine gute Aktivität bei UC-Patient:innen, die refraktär gegenüber multiplen Therapielinien, darunter auch EV, waren.10 „Ein Wirkstoff, der künftig im fortgeschrittenen oder metastasierten UC-Setting eine Rolle spielen wird, ist der EGFR-plus-HER3-bispezifische ADC Izalontamab-Brengitecan“, so Prof. Dr. Rosenberg. Eine initiale Studie zeigte vielversprechende Daten und eine dreiarmige Phase-II/III-Studie ist in Planung. Diese soll untersuchen, welche Ansätze nach einem Versagen von EV plus Pembrolizumab wirkungsvoll sein können.11 Neben Nectin-4 und Trop2 werden auch HER2-gerichtete ADC wie Disitamab-Vedotin künftig die Therapie des UC bereichern.12
Active Surveillance
Das Management des muskelinvasiven Blasenkarzinoms (MIBC) hat sich durch wirkungsvollere und intensivere systemische Therapien verbessert. „Dies erlaubt es, darüber nachzudenken, in welchen Fällen eine radikale Zystektomie vermieden und bei welchen Patient:innen Therapien deeskaliert werden könnten“, so Prof. Dr. Peter Black von der University of British Columbia, USA. Es mangelte bisher an Erfahrungen mit Active-Surveillance(AS)-Ansätzen nach neoadjuvanter Therapie und zum Staging der Patient:innen. So hat trotz Bildgebung und multipler Biopsien bis zu 1/3 der Patient:innen nach cisplatinbasierter neoadjuvanter Chemotherapie (NAC) eine residuale MIBC, wenn die Blase nicht entfernt wird.13,14 Die verfügbaren Methoden für das Monitoring wie Urinzytologie, CT-Scans und Zystoskopie/transurethrale Resektion des Blasenkarzinoms (TURBT) scheinen unzureichend zu sein.
Therapieansätze mit Blasenerhalt
Ein Hinweis, dass ein Blasenerhalt möglich ist, kam aus retrospektiven Studien, die zeigen konnten, dass bei Patient:innen mit einer klinischen vollständigen Remission (CR) nach neoadjuvanter NAC eine hohe 5-Jahres-Gesamtüberlebensrate erzielt werden konnte. Es handelte sich um eine sehr kleine, selektive Subpopulation.14 Auch Biomarker kamen in den Fokus, als gezeigt wurde, dass ein Vorliegen von Veränderungen in Genen der DNA-Damage-Response (DDR) wie ERCC2, ATM, FANCC und RB1 mit einer hohen Rate an pathologischem Komplettansprechen nach einer Cisplatin-haltigen neoadjuvanten CT assoziiert war. Dies wurde in mehreren Studien weiterführend analysiert: In der RETAIN-Studie (n=70) wurden MIBC-Patient:innen (n=71) mit 3 Zyklen ddMVAC behandelt. Patient:innen mit zugrunde liegender DDR-Mutation, die mit einer CR auf die Therapie ansprachen, konnten optional eine AS erhalten. 68% dieser Patient:innen erlitten ein Rezidiv und 36% entwickelten Metastasen.15 In der RETAIN-2-Studie (n=80) wurde neoadjuvant zusätzlich der ICI Nivolumab gegeben. Unter der Therapie waren 84% der Patient:innen mit DDR-Mutation und klinischem CR nach median 21,7 Monaten weiterhin frei von Metastasen.16 In der HCRN-GU16-257-Studie erhielten MIBC-Patient:innen (n=72) 4 Zyklen Gemcitabin/Cisplatin (G/C) plus Nivolumab. Nach der Behandlung erfolgte ein detailliertes Restaging und Patient:innen mit CR, die einem AS-Ansatz mit adjuvant 8 Zyklen Nivolumab zustimmten, hatten ein signifikant verlängertes metastasenfreies Überleben und OS (Abb. 1).17
„Die Daten legten nahe, dass mit adäquatem Staging und Restaging und unter Hinzunahme einer Immuntherapie die AS eine vielversprechende Strategie darstellen kann“, erklärte Black. Aktuelle Studien, wie NEO-BLAST, knüpfen hieran an und inkludieren eine Vielzahl an Methoden wie Zytologie, CT, TURBT, MRI, utDNA und ctDNA für ein detailliertes (Re-)Staging nach einer Therapie mit G/C plus Nivolumab, um die bestmögliche Patient:innenpopulation für eine AS zu identifizieren.18 Diese neuen Studien könnten zu einem Paradigmenwechsel in der Behandlung des MICB führen, bei dem ein möglicher Blasenerhalt im Vordergrund steht.
Dynamische Therapielandschaft
„Im Setting des nicht muskelinvasiven BC (NMIBC) hat sich in den letzten 10 Jahren kaum etwas verändert; in Zukunft könnten neue Therapieoptionen auf den Markt kommen“, so Dr. med. Félix Guerrero-Ramos von der ROC-Klinik in Madrid, Spanien. Für Patient:innen mit niedrigem oder intermediärem Risiko ist eine sofortige intravesikale CT der Standard. Bei intermediärem Risiko kommt eine einjährige Bacillus-Calmette-Guérin-Therapie (BCG) infrage, die im Hochrisiko-Setting auf bis zu 3 Jahre verlängert werden kann. Zwar gab es bisher noch keine Änderungen für die Praxis, aber gerade der Erfolg ablativer Ansätze könnte in Zukunft eine zentrale Rolle in der Behandlung des NMIBC spielen.19 Im Hochrisikosetting sollte neben BCG auch eine radikale Zystektomie diskutiert werden.20 Die BCG ist seit 1976 die Standardtherapie für das Hochrisiko-NMIBC. Rezent wurden mehrere Studien zu Therapiealternativen bei BCG-Naivität veröffentlicht: In der CREST-Studie konnte durch eine Kombination aus dem Anti-PD-1-Antikörper Sasanlimab plus BCG das ereignisfreie Überleben (EFS) gegenüber BCG allein signifikant verlängert werden und Patient:innen hatten ein um 31% niedrigeres Risiko für ein EFS-Event.21
Die POTOMAC-Studie untersuchte den Nutzen einer einjährigen Behandlung mit dem ICI Durvalumab in Kombination mit einer BCG-Induktions- und Erhaltungstherapie und konnte eine signifikante und klinisch bedeutsame Verlängerung des krankheitsfreien Überlebens im Vergleich zu alleiniger BCG-Therapie erzielen.22 Eine ähnliche Studie, ALBAN, die eine Kombinationstherapie mit dem ICI Atezolizumab plus BCG untersuchte, zeigte jedoch keine signifikanten Verbesserungen.23 Die KEYNOTE-676-Studie untersucht die Wirksamkeit und Sicherheit von Pembrolizumab plus BCG im Vergleich zu einer BCG-Monotherapie bei Patient:innen mit persistierendem/rezidivierendem Hochrisiko-NMIBC nach BCG-Induktionstherapie. Hier werden die Daten der Kohorte B (papilläre Erkrankung ohne Carcinoma in situ) erwartet.24 „Ansätze ohne BCG werden derzeit erforscht, z.B. die SunRISe-3, die den Nutzen des intravesikalen Arzneimittelabgabesystems TAR-200 untersucht“, schließt Dr. med. Guerrero-Ramos.25,26
Quelle:
11. Michael J. Marberger Meeting der Universitätsklinik für Urologie der Medizinischen Universität, 10.–12. 12. 2025
Literatur:
1 Perera A et al.: Antibody-drug conjugates in urothelial, prostate, and renal cell cancers: A review of current and emerging therapies. Crit Rev Oncol Hematol 2026; 218: 105067 2 Chatterjee S et al.: Nectin cell adhesion molecule-4 (NECTIN-4): A potential target for cancer therapy.Eur J Pharmacol 2021; 911: 174516 3 Challita-Eid PM et al.: Enfortumab vedotin antibody-drug conjugate targeting nectin-4 is a highly potent therapeutic agent in multiple preclinical cancer models. Cancer Res 2016; 76(10): 3003-13 4 Rosenberg JE et al.: Pivotal trial of enfortumab vedotin in urothelial carcinoma after platinum and anti-programmed death 1/programmed death ligand 1 therapy. J Clin Oncol 2019; 37(29): 2592-600 5 Rosenberg J et al.: EV-101: A phase I study of single-agent enfortumab vedotin in patients with nectin-4-positive solid tumors, including metastatic urothelial carcinoma. J Clin Oncol 2020; 38(10): 1041-9 6 Powles T et al.: Enfortumab vedotin in previously treated advanced urothelial carcinoma. N Engl J Med. 2021; 384(12): 1125-35 7 Fachinformation Padcev, Stand 09/2025 8 Powles T et al.: Enfortumab vedotin and pembrolizumab in untreated advanced urothelial cancer. N Engl J Med 2024; 390(10): 875-88 9 Zhang J et al.: J Clin Oncol 2024; 42: Suppl 16 abstr 3013 10 Meric-Bernstam F et al.: J Clin Oncol. 2025; 43: 5_suppl abstract 663 11 Bian X et al.: Efficacy and safety of BL-B01D1 in patients with locally advanced or metastatic urothelial carcinoma: a phase II clinical trial. J Clin Oncol 2025; 43(32): 3505-15 12 Galsky MD et al.: Annals of Oncol 2024; 35: Suppl 2 S1138-S1139 13 Robins D et al.: Outcomes following clinical complete response to neoadjuvant chemotherapy for muscle-invasive urothelial carcinoma of the bladder in patients refusing radical cystectomy. Urology 2018; 111: 116-21 14 Mazza P et al.: Conservative management following complete clinical response to neoadjuvant chemotherapy of muscle invasive bladder cancer: contemporary outcomes of a multi-institutional cohort study. J Urol 2018; 200(5): 1005-13 15 Geynisman DM et al.: Phase II Trial of risk-enabled therapy after neoadjuvant chemotherapy for muscle-invasive bladder cancer (RETAIN 1). J Clin Oncol 2025; 43(9): 1113-22 16 Ghatalia P et al.: ASCO 2025 GU25 17 Galsky MD et al.: Author Correction: Gemcitabine and cisplatin plus nivolumab as organ-sparing treatment for muscle-invasive bladder cancer: a phase 2 trial. Nat Med 2024; 30(4): 1211 18 St-Laurent MP et al.: J Clin Oncol 2025; 43: 10.1200/JCO.2025.43.5_suppl.TPS890 19 Guerrero-Ramos F et al.: Novel delivery systems and pharmacotherapeutic approaches for the treatment of non-muscle-invasive bladder cancer. Eur Urol Oncol 2024; 7(6): 1267-79 20 EAU Guidelines on NMIBC 2025 21 Shore ND et al.: Sasanlimab plus BCG in BCG-naive, high-risk non-muscle invasive bladder cancer: the randomized phase 3 CREST trial. Nat Med 2025; 31(8): 2806-14 22 De Santis M et al.: Durvalumab in combination with BCG for BCG-naive, high-risk, non-muscle-invasive bladder cancer (POTOMAC): final analysis of a randomised, open-label, phase 3 trial. Lancet 2025; 406(10516): 2221-34 23 Roupret M et al.: ALBAN (GETUG-AFU 37): a phase III, randomized, open-label international trial of intravenous atezolizumab and intravesical Bacillus Calmette-Guérin (BCG) versus BCG alone in BCG-naive high-risk, non-muscle-invasive bladder cancer (NMIBC). Ann Oncol 2026; 37(1): 44-52 24 Kamat AM et al.: KEYNOTE-676: Phase III study of BCG and pembrolizumab for persistent/recurrent high-risk NMIBC. Future Oncol 2020; 16(10): 507-16 25 Necchi A et al.: Ann Oncol 2023; 34: S1224 10.1016/j.annonc.2023. 09.2825 26 Kates M et al.: Background and update for ECOG-ACRIN EA8212: A randomized phase 3 trial of intravesical Bacillus Calmette-Guérin (BCG) Versus intravesical docetaxel and gemcitabine treatment in BCG-naïve high-grade non-muscle-invasive bladder cancer (BRIDGE). Eur Urol Focus 2023; 9(4): 561-3
Das könnte Sie auch interessieren:
Erstes „Da Vinci Single Port“-OP-System in Österreich
Seit März 2025 werden an der Klinik Oberwart robotisch assistierte Eingriffe mit dem „Da Vinci Single Port“(SP)-Operationssystem durchgeführt. Prim. Dr. Gottfried Pfleger berichtet über ...
Heutiger Stellenwert der ESWL: Renaissance in Sicht?
Die ESWL (extrakorporale Stoßwellenlithotrypsie) ist eine Technik zur urologischen Steintherapie, die in den 80er-Jahren des vorigen Jahrhunderts in den klinischen Alltag Einzug gehalten ...
PCNL-Indikationen in Zeiten von flexibler Ureterorenoskopie mit Absaugung?
In der Behandlung von Nierensteinen, die größer als 2cm sind, spielt die perkutane Nephrolithotomie (PCNL) weiterhin eine wichtige Rolle. Die flexible Ureterorenoskopie (URS) mit ...
.jpg)

